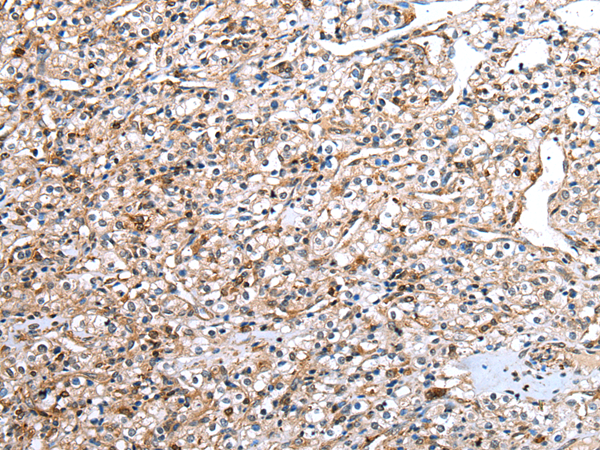

Order NO. D223570
产品描述
概述
This gene encodes a protein with multiple WD40 repeats which facilitate protein-protein interactions and thereby enable the assembly of multiprotein complexes. This protein has been shown to function as a scaffold protein for protein complexes involved in kinase signaling. This highly conserved gene is present in eukaryotic plants, fungi, and animals. The ortholog of this gene was first identified in plants as a key regulator of anthocyanin biosynthesis and flower pigmentation.
应用
酶联免疫吸附测定(ELISA),免疫印迹(WB),免疫组织化学(IHC)
属性
| 保存缓冲液 |
-20°C, pH7.4 PBS, 0.05% NaN3, 40% Glycerol
|
| 运输条件 |
2-8°C
|
| 靶点 Uniprot 登记号 |
P61962
|
| 靶点基因 ID |
10238
|
| 靶点全称 |
DDB1 and CUL4 associated factor 7
|
| 靶点别名 |
AN11; HAN11; WDR68; SWAN-1
|
| 靶点研究领域 |
Signal Transduction, Cell Biology
|
| 亚型 |
Immunogen-specific rabbit IgG
|